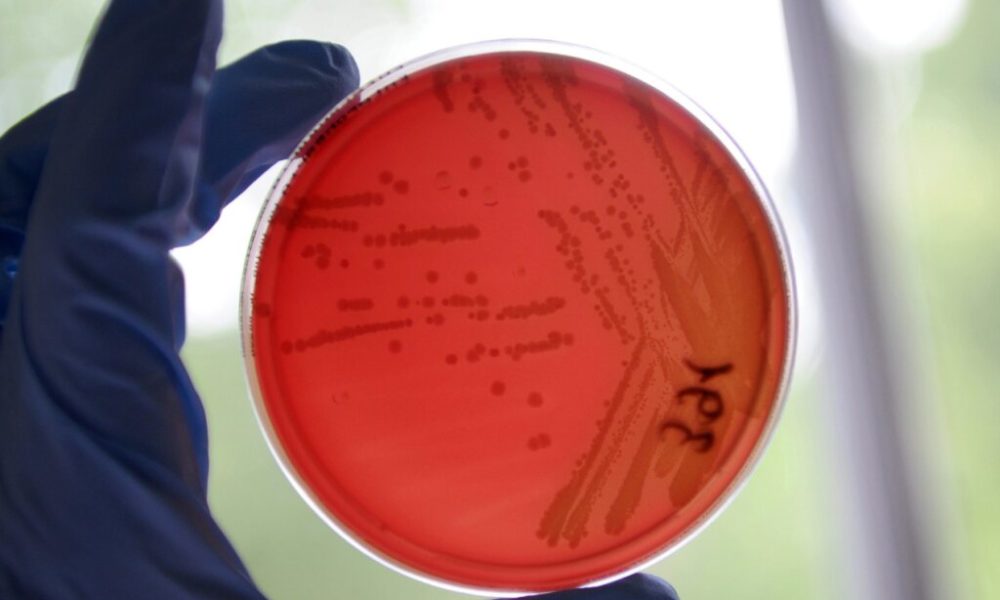

Une équipe genevoise a découvert qu’un médicament contre l’herpès permet de lutter contre une bactérie résistante à la plupart des antibiotiques. Cette molécule fragilise la surface...



Peut-on arrêter de prendre des antibiotiques avant la fin de notre traitement ? Les messages officiels, souvent, nous disent qu’ "un traitement antibiotique doit être suivi...